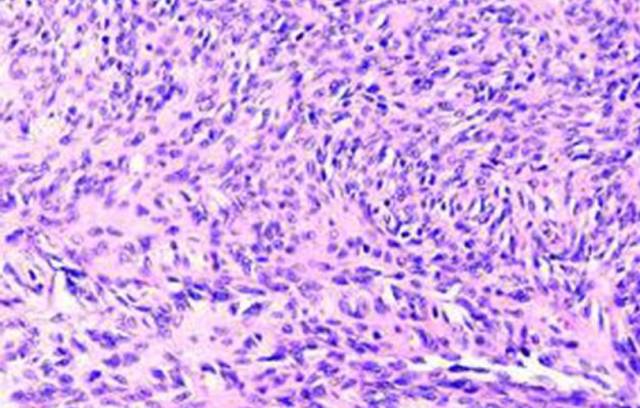
ͼƬ

1、免疫组化实验所用的组织和细胞标本有哪些?
实验所用主要为组织标本和细胞标本两大类,前者包括石蜡切片(病理大片和组织芯片)和冰冻切片,后者包括组织印片、细胞爬片和细胞涂片。其中石蜡切片是制作组织标本最常用、最基本的方法,对于组织形态保存好,且能作连续切片,有利于各种染色对照观察;还能长期存档,供回顾性研究;石蜡切片制作过程对组织内抗原暴露有一定的影响,但可进行抗原修复,是免疫组化中首选的组织标本制作方法。
2、石蜡切片为什么要做抗原修复?有哪些方法?
石蜡切片标本均用甲醛固定,使得细胞内抗原形成醛键、羧甲键而被封闭了部分抗原决定簇,同时蛋白之间发生交联而使抗原决定簇隐蔽。所以要求在进行IHC染色时,需要先进行抗原修复或暴露,即将固定时分子之间所形成的交联破坏,而恢复抗原的原有空间形态。常用的抗原修复方法有微波修复法,高压加热法,酶消化法,水煮加热法等,常用的修复液是pH6.0的0.01 mol/L的柠檬酸盐缓冲液。
3、免疫组化常用的染色方法有哪些?
根据标记物的不同分为免疫荧光法,免疫酶标法,亲和组织化学法,后者是以一种物质对某种组织成分具有高度亲合力为基础的检测方法。这种方法敏感性更高,有利于微量抗原(抗体)在细胞或亚细胞水平的定位,其中生物素――抗生物素染色法最常用。
4、石蜡切片在染色过程中出现脱片现象
1)烤片时间不够,或温度不够,可以延长烤片时间和提高烤片温度;
2)用含有多聚赖氨酸的玻片,可以购买到或这自己做;
3)有些组织本身就容易掉片,如骨组织等,操作时冲PBS不要直接冲到组织上,冲到组织上方,让它流下冲洗组织;
4)用高温修复时,温度骤冷也可能引起。
5、边缘效应
1)组织边缘与玻片粘贴不牢,边缘组织松脱漂浮在液体中,每次清洗不易将组织下面试剂洗尽所致. 解决办法:制备优质的胶片(APES或多聚赖氨酸),切出尽量薄的组织切片,不厚于4微米,组织的前期处理应规范,尽量避免选用坏死较多的组织;
2)切片上滴加的试剂未充分覆盖组织,边缘的试剂容易首先变干,浓度较中心组织高而致染色深。解决办法:试剂要充分覆盖组织,应超出组织边缘2mm。用组化笔画圈时,为了避免油剂的影响,画圈应距组织边缘3-4mm。
6、产生组织切片非特异性染色
1)抗体孵育时间过长、抗体浓度高易增加背景着色。这可通过缩短一抗/二抗孵育时间、稀释抗体来控制。这是最重要的一条;
2)一抗用多克隆抗体易出现非特异性着色,建议试用单克隆抗体看看;
3)内源性过氧化物酶和生物素在肝脏、肾脏等组织含量很高(含血细胞多的组织),需要通过延长灭活时间和增加灭活剂浓度来降低背景染色;
4)非特异性组分与抗体结合,这需要通过延长二抗来源的动物免疫血清封闭时间和适当增加浓度来加强封闭效果;
5)DAB孵育时间过长或浓度过高;
6)PBS冲洗不充分,残留抗体结果增强着色,在一抗、二抗或SP孵育之后的浸洗尤为重要;
7)标本染色过程中经常出现干片,这容易增强非特异性着色。
7、免疫组化染色呈阴性结果
1)抗体浓度和质量问题以及抗体来源选择错误;
2)抗原修复不全,对于甲醛固定的组织必须用充分抗原修复来打开抗原表位,以利于与抗体结合;建议微波修复用高火4次*6min试试。有人做过实验,这是最佳的时间和次数。若不行,还可高压修复;
3)组织切片本身这种抗原含量低;
4)血清封闭时间过长;
5)DAB孵育时间过短;
6)细胞通透不全,抗体未能充分进入胞内参与反应;
7)开始做免疫组化,我建议你一定要首先做个阳性对照片,排除抗体等外的方法问题。
8、背景
1)考虑一抗浓度高;
2)然后调整DAB孵育时间;
3)也要考虑血清封闭时间是否过短;
4)适当增加抗体孵育后的浸洗次数和延长浸洗时间等。
|